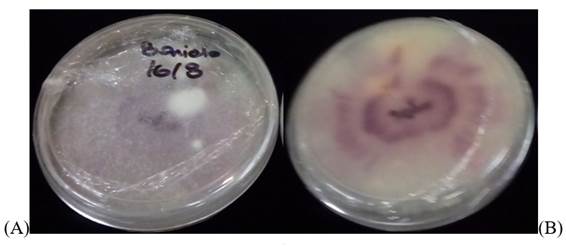

1. Introduction
Among the horticultural items commercialized in 2017 in the Wholesale Market of Montevideo, Uruguay, the sweet potato (Ipomoea batatas L & Lamb) takes the fifth place if the physical volume is taken into account, and the sixth place when considering the monetary value. Uruguayans are estimated to consume 5 to 7 kg annually1. It is produced by 1,150 family businesses, of which 93.4% cultivate between 0.5 and 3 hectares of sweet potato2. 86% of these small farmers are located in the southern region3, mainly in the department of Canelones.
National production supplies the demand of the Uruguayan population in the period that runs from January to November. From September until the following harvest, the national supply decreases and it is necessary to import, although in reduced volumes. From 2015 to 2018, annual imports ranged between 0 and 13% of the volume that entered the Wholesale Model Market (2018, conversation with P. Pacheco and Romero, unreferenced).
The harvest takes place between January and April and must be followed by immediate “curing” before storage, so that the healing periderm can be formed. This process is carried out in the field under conditions of temperature and relative humidity that depend on the climate and soil variability. Conditions are not always adequate to achieve correct healing of the wounds produced during harvest because they are frequently outside the optimal healing temperature range determined between 29 and 32 ºC, and around 85% RH.4)(5, producing a slower and incomplete suberization that favors F. oxysporum penetration in the reserve root5)(6.
Many producers in the department of Canelones adopt the strategy of staggered commercialization, that allows them to obtain periodic monetary income for several months. For this purpose, part of the production is conserved in storage structures that differ between producers and even in the same farm, all without artificial regulation of temperature or relative humidity. This determines an important variability in both variables in the storage period, which are frequently outside the optimal range of 13-16 ºC and 85% relative humidity, adequate to maintain the physiological and sanitary quality of the stored sweet potato4)( 5)(6)(7.
Different pathogens that infect the reserve root penetrate mainly during harvest and develop during conservation, producing different types of rot that are an important cause of losses that occur in storage, which are greater the longer this is.
Maeso and Vilaró 8 identified Pellicularia filamentosa, Sclerotinia sclerotiorum, Sclerotium rolfsii, Plenodomus destruens, Monilochaetes infuscans, Albugo ipomoeae-panduratae, Rhizopus stolonifer, and Fusarium oxysporum causing sweet potato diseases. Monteiro9 identified the presence of Plenodomus destruens, Phomopsis batatis, Ceratocystis fimbriata, Monilochaetes infuscans, Pythium spp, Fusarium spp, and Rhizopus nigricans in stored sweet potatoes.
During sweet potato storage, the frequent appearance of dry, circular, dark, slightly sunken cankers of variable size was observed in recent years. They are not normally visible at first sight when harvested, but become visible and increase in quantity and size during storage, and may coalesce.
This type of lesions is similar to that described by Clark and Moyer4 for the superficial rot produced by F. oxysporum, described as circular, dark brown to pale, firm, dry, superficial, and external to the vascular ring. When extended storage, the tissues in and around the lesions dry out and wrinkle, and the roots can mummify. Root rot caused by F. solani is also described, producing circular lesions and commonly showing dark and pale brown concentric rings, surpassing the vascular ring through the center and being able to take the entire root. The tissue turns orange to pale brown on the margin of the lesion. Older lesions become dry and lens-shaped cavities appear in the pulp, with white hyphae sometimes visible inside. In some cases, surface rot is a preliminary stage of root rot. The two species can be differentiated by the morphology of the colonies, asexual spores and molecular methods4)(9)(10)(11.
Several authors have identified different Fusarium species that infect the sweet potato reserve root4)(9. In a survey carried out in North Carolina (usa), six species of Fusarium were identified, corresponding to F. solani 43% and F. oxysporum 39% of the total isolations7.
Regarding F. oxysporum, the soil is the inoculum source from which it infects the reserve root. It survives as chlamydospores when environmental conditions are adverse, or in the absence of host plants, allowing the fungus to be present in the soil for a long time. However, little is known about the population dynamics in the soil4)(9)(12.
Unlike F. solani, that causes cankers on the stem of the transplanted cuttings decreasing the yield of sweet potatoes, this pathogen does not spread from the infected root used as “seed” to the shoots (cuttings) it produces4.
F. oxysporum requires wounds to infect the reserve root and in storage, it does not spread from infected roots to other healthy roots unless new wounds occur4. When the infected sweet potatoes are stored under optimal temperature and relative humidity conditions (13-16 ºC and 85% RH), the disease progresses slowly4)(12, given that the cardinal optimal temperatures of fungus development are between 25 ºC and 30 ºC10. Genetic resistance to F. oxysporum has been studied by different researchers, evaluating the behavior of commercial cultivars and selections. Research shows differences in the degree of susceptibility, but the scientific evidence is not consistent enough with respect to materials that genetically possess qualitative resistance5)(6)(12)(13.
The objectives of this study were: to identify the species of the isolated pathogen from the predominant lesions observed in sweet potatoes stored under different conditions of Canelones production; to verify the causal relationship between the pathogen and the symptoms; to contribute to the study of its epidemiology, and to design management strategies that minimize losses at harvest and during storage.
2. Material and methods
From 2012 to 2016, a directed sampling was carried out at four storage sites of producers Cerrillos, San Antonio, Sauce, and Progreso regions of Canelones department. A total of twenty sweet potato samples with symptoms of dry circular, dark, slightly sunken cankers were taken from the cultivars Cuarí, Baqueano, Beauregard, Cuará, and Cambará. Each sample, which consisted of 10 sweet potatoes, was identified with the variety and date and was sent to the Diagnostic Clinic of the Plant Protection Department of the Agronomy Faculty, University of the Republic, Uruguay.
The symptoms were observed macro and microscopically, externally and internally, and photographed. To identify the fungi by morphology, the signs were studied directly on the sample in the cases that were detected, but in all of them, the structures were studied from isolates10)(11.
To start the isolation process, a sweet potato with incipient and characteristic symptoms was chosen from the sample. After disinfection, cuts from the transitional tissue between the affected and healthy areas were removed. Those sections were sterilized, immersing them for one minute in 70% alcohol, rinsed twice with sterile distilled water, dried in a laminar flow chamber, and seeded in Potato Dextrose Agar culture medium (PDA, Oxoid. CMO139). Subsequently, they were incubated at 24 ºC and in the dark for approximately five days. The developed colonies were replicated to obtain pure cultures and to begin with the morphological identification that was carried out with colonies between 5 and 7 days old10)(11. The fungi that appeared most frequently were kept on sterile filter paper. They were subsequently recovered to perform molecular characterization and pathogenicity tests.
The dna was extracted from two colonies with seven days of growth in pda medium for molecular identification, using the protocol described by Delgado-Cerrone14. For each isolate part of the elongation factor one alpha gene (EF1α) was amplified and sequenced with the primers EF1-728F / EF1-986R15. Amplifications were performed using a MultiGene™ Mini thermocycler (Labnet International Inc., usa) in a final volume of 20 µL. Amplified products were purified and sequenced at Macrogen Inc. (Seoul, Korea). The sequences obtained were aligned with Clustal W included in the mega 7.0.2616) program. The phylogenetic reconstruction was performed for the EF1α region data set with the Maximum Likelihood (ml) method, including sequences from similar species and close to those obtained, extracted from the GenBank database. The missing spaces or data generated in the alignment were considered complete deletions. The estimation of the value of the nodes was obtained through 1000 Bootstrap repetitions.
Sweet potatoes without visible symptoms of disease were used to carry out the pathogenicity test. Each one was superficially disinfected with 70% alcohol, just like the instruments used. The ends were discarded and the rest was cut into three sections. Half were inoculated with the most frequently obtained fungus and the rest remained uninoculated as control.
To inoculate the sweet potato sections, 2 cm diameter discs of the culture medium were placed on the cut area with 6-day-old fungal colony mycelium. The plant material thus inoculated was kept in a humid chamber at 23 ºC and a 12-hour photoperiod. Symptoms were documented after about a month and a half. The fungus was re-isolated and the same identity of the inoculated fungus could be verified with its morphological identification, thus fulfilling Koch's postulates.
3. Results and discussion
All received samples presented the symptoms of superficial circular cankers that minimally affected the underlying tissue, from pale brown to blackish and dry colors, with an average diameter of 2 to 4 mm at the beginning, that could grow and coalesce, generating more extensive dark areas (Figure 1). In some of these injuries, a detachment of the skin between the affected and the healthy tissue was observed.
38 fungal isolates were obtained from the seeding of the transitional tissue sections in the culture medium. 85% of these were white colonies with purplish-pink tones characteristic of many Fusarium species (Figure 2). The rest of the isolates corresponded to the genera Alternaria, Verticillium, and Penicillium.
In the morphological identification of the colonies, the presence of predominantly oval microconidia of 6.4 by 3 um in the aerial mycelium was found in false heads on short monofialides, and scarce medium-sized macroconidia of 27 by 3.8 um and straight (Figure 3). The mentioned characteristics corresponded to Fusarium oxysporum11)(12, confirmed by molecular identification as explained below.
An amplification of approximately 560 bp was obtained from the elongation factor one alpha region of two sweet potato isolates. Sequence analysis by ml resulted in a tree with three clades (Figure 4). Isolates 8 and 10 were included in the clade that groups the species F. oxysporm, with Bootstrap support of 99%.

Figure 4: Tree generated from the phylogenetic analysis of EF1α sequences by Maximum likelihood of two sweet potato isolates obtained in this study, and sequences of reference isolates obtained from GenBank. The values in the nodes correspond to Bootstrap support (%) for 1000 repetitions.
In the pathogenicity test, dry rot was obtained that tended to grow towards the center of the sectioned sweet potato and in re-isolation F. oxysporum was identified again. Therefore, the pathogenicity of F. oxysporum and its causal relationship with the cankers described in the studied samples were confirmed. This rot matches with Clark and Moyer4 description of the injuries caused by F. oxysporum.
The five studied cultivars presented lesions caused by F. oxysporum, which show that none of them possessed qualitative resistance. This agrees with the investigations of Nielsen5, Scott and others12, and Nielsen and Johnson6, who found no qualitative resistance among the materials they evaluated, although they did identify different susceptibility degrees. One of the practices to consider in integrated crop management is choosing cultivars with a lower susceptibility level to F. oxysporum. For this, work on genetic improvement should include this evaluation, both of the materials under selection and of the cultivars currently planted.
F. oxysporum persists in the soil for a long time, mainly as chlamydospores, and penetrates mainly through the wounds caused by harvesting4. Producers harvest the sweet potato under variable conditions of temperature and relative humidity, and the “curing” is carried out in the field, frequently outside the optimum temperature range of 29 ºC and 32 ºC and around 85% RH, which allow rapid and complete healing of the periderm4)(5)(6)(17. This condition substantially favors infection.
Technically, artificial “curing” would be the best option, particularly if the sweet potato is meant to be stored for a long time, but currently, it is not economically feasible to invest in structures specially built for that purpose. Therefore, careful management of the harvest to minimize injuries and the identification of the optimal harvest date so that curing is carried out with the temperature and relative humidity closest to optimal are subjects to study.
In storage, temperatures between 13 and 16 ºC and relative humidity of 85% slow down the development in the already infected sweet potatoes. The pathogen does not spread from infected roots to healthy ones unless new wounds occur4)(5)(6)(7.
Therefore, it is necessary to study the type of structures that allow the temperature and relative humidity to be kept as close as possible to the optimal values mentioned, affordable by the family producers of Canelones.
It is suggested to continue deepening the knowledge of the epidemiological factors that affect the infection and virulence of the pathogen during cultivation, harvest, “curing” and storage. These elements will contribute to establishing the most appropriate management and control practices to avoid or reduce post-harvest losses and deterioration in the commercial quality of the sweet potato.
4. Conclusions
The techniques used for the morphological and molecular characterization, and the reproduction of the symptoms in the pathogenicity test allowed to identify F. oxysporum and to confirm that it is the causal organism of superficial circular cankers that minimally affect the underlying tissue. Pale brown to blackish and dry, with an average diameter of 2 to 4 mm, which may coalesce, generating more extensive dark areas, and skin detachment may occur between the affected and the healthy tissue.
The five sweet potato cultivars studied presented the characteristic lesions produced by F. oxysporum, which indicate that they are all susceptible.
The identification of the causal agent of the described symptoms is a contribution to future epidemiological studies, it contributes to a better understanding of post-harvest rot and to define a more precise combination of appropriate management practices for the integrated control of this disease in Canelones production conditions.